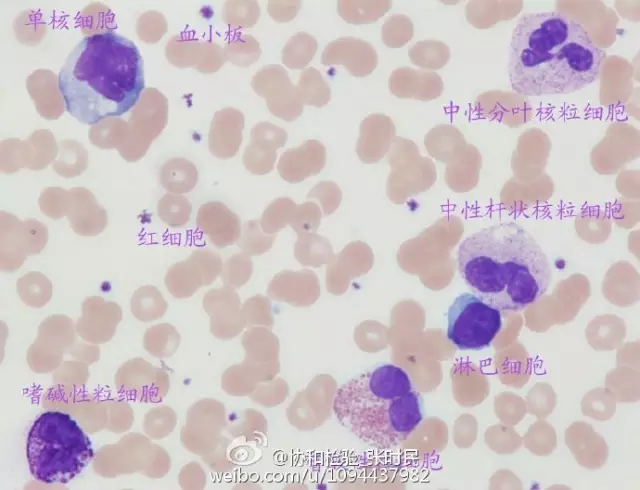
20160428135154 625e8
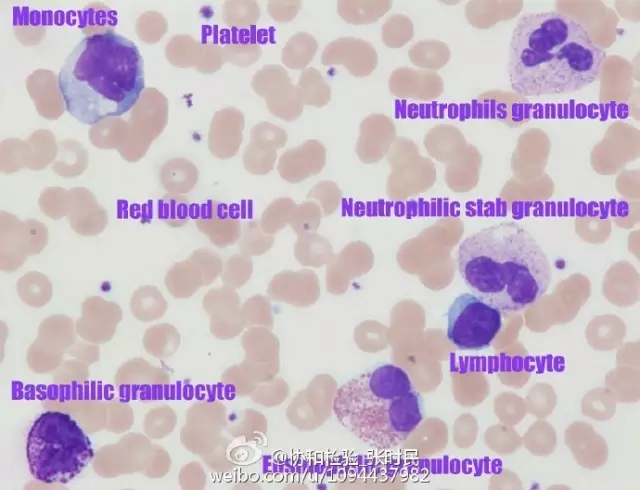
20160428135201 21c11

昨天拍到的,人体血液细胞家族大聚会(中英文版),有这一个视野就够了,已经学习全面了吧。


(内容来源于协和检验_张时民新浪微博,转载出于传递更多信息之目的,版权和荣誉归原作者所有。如有侵权请联系我们妥善处理!)
血液细胞家族大聚会
2016-04-28
昨天拍到的,人体血液细胞家族大聚会(中英文版),有这一个视野就够了,已经学习全面了吧。

(内容来源于协和检验_张时民新浪微博,转载出于传递更多信息之目的,版权和荣誉归原作者所有。如有侵权请联系我们妥善处理!)
艾迪康医学检验中心 © 版权所有 法律声明 浙ICP备07020270号-1 浙公网安备33010602009212号